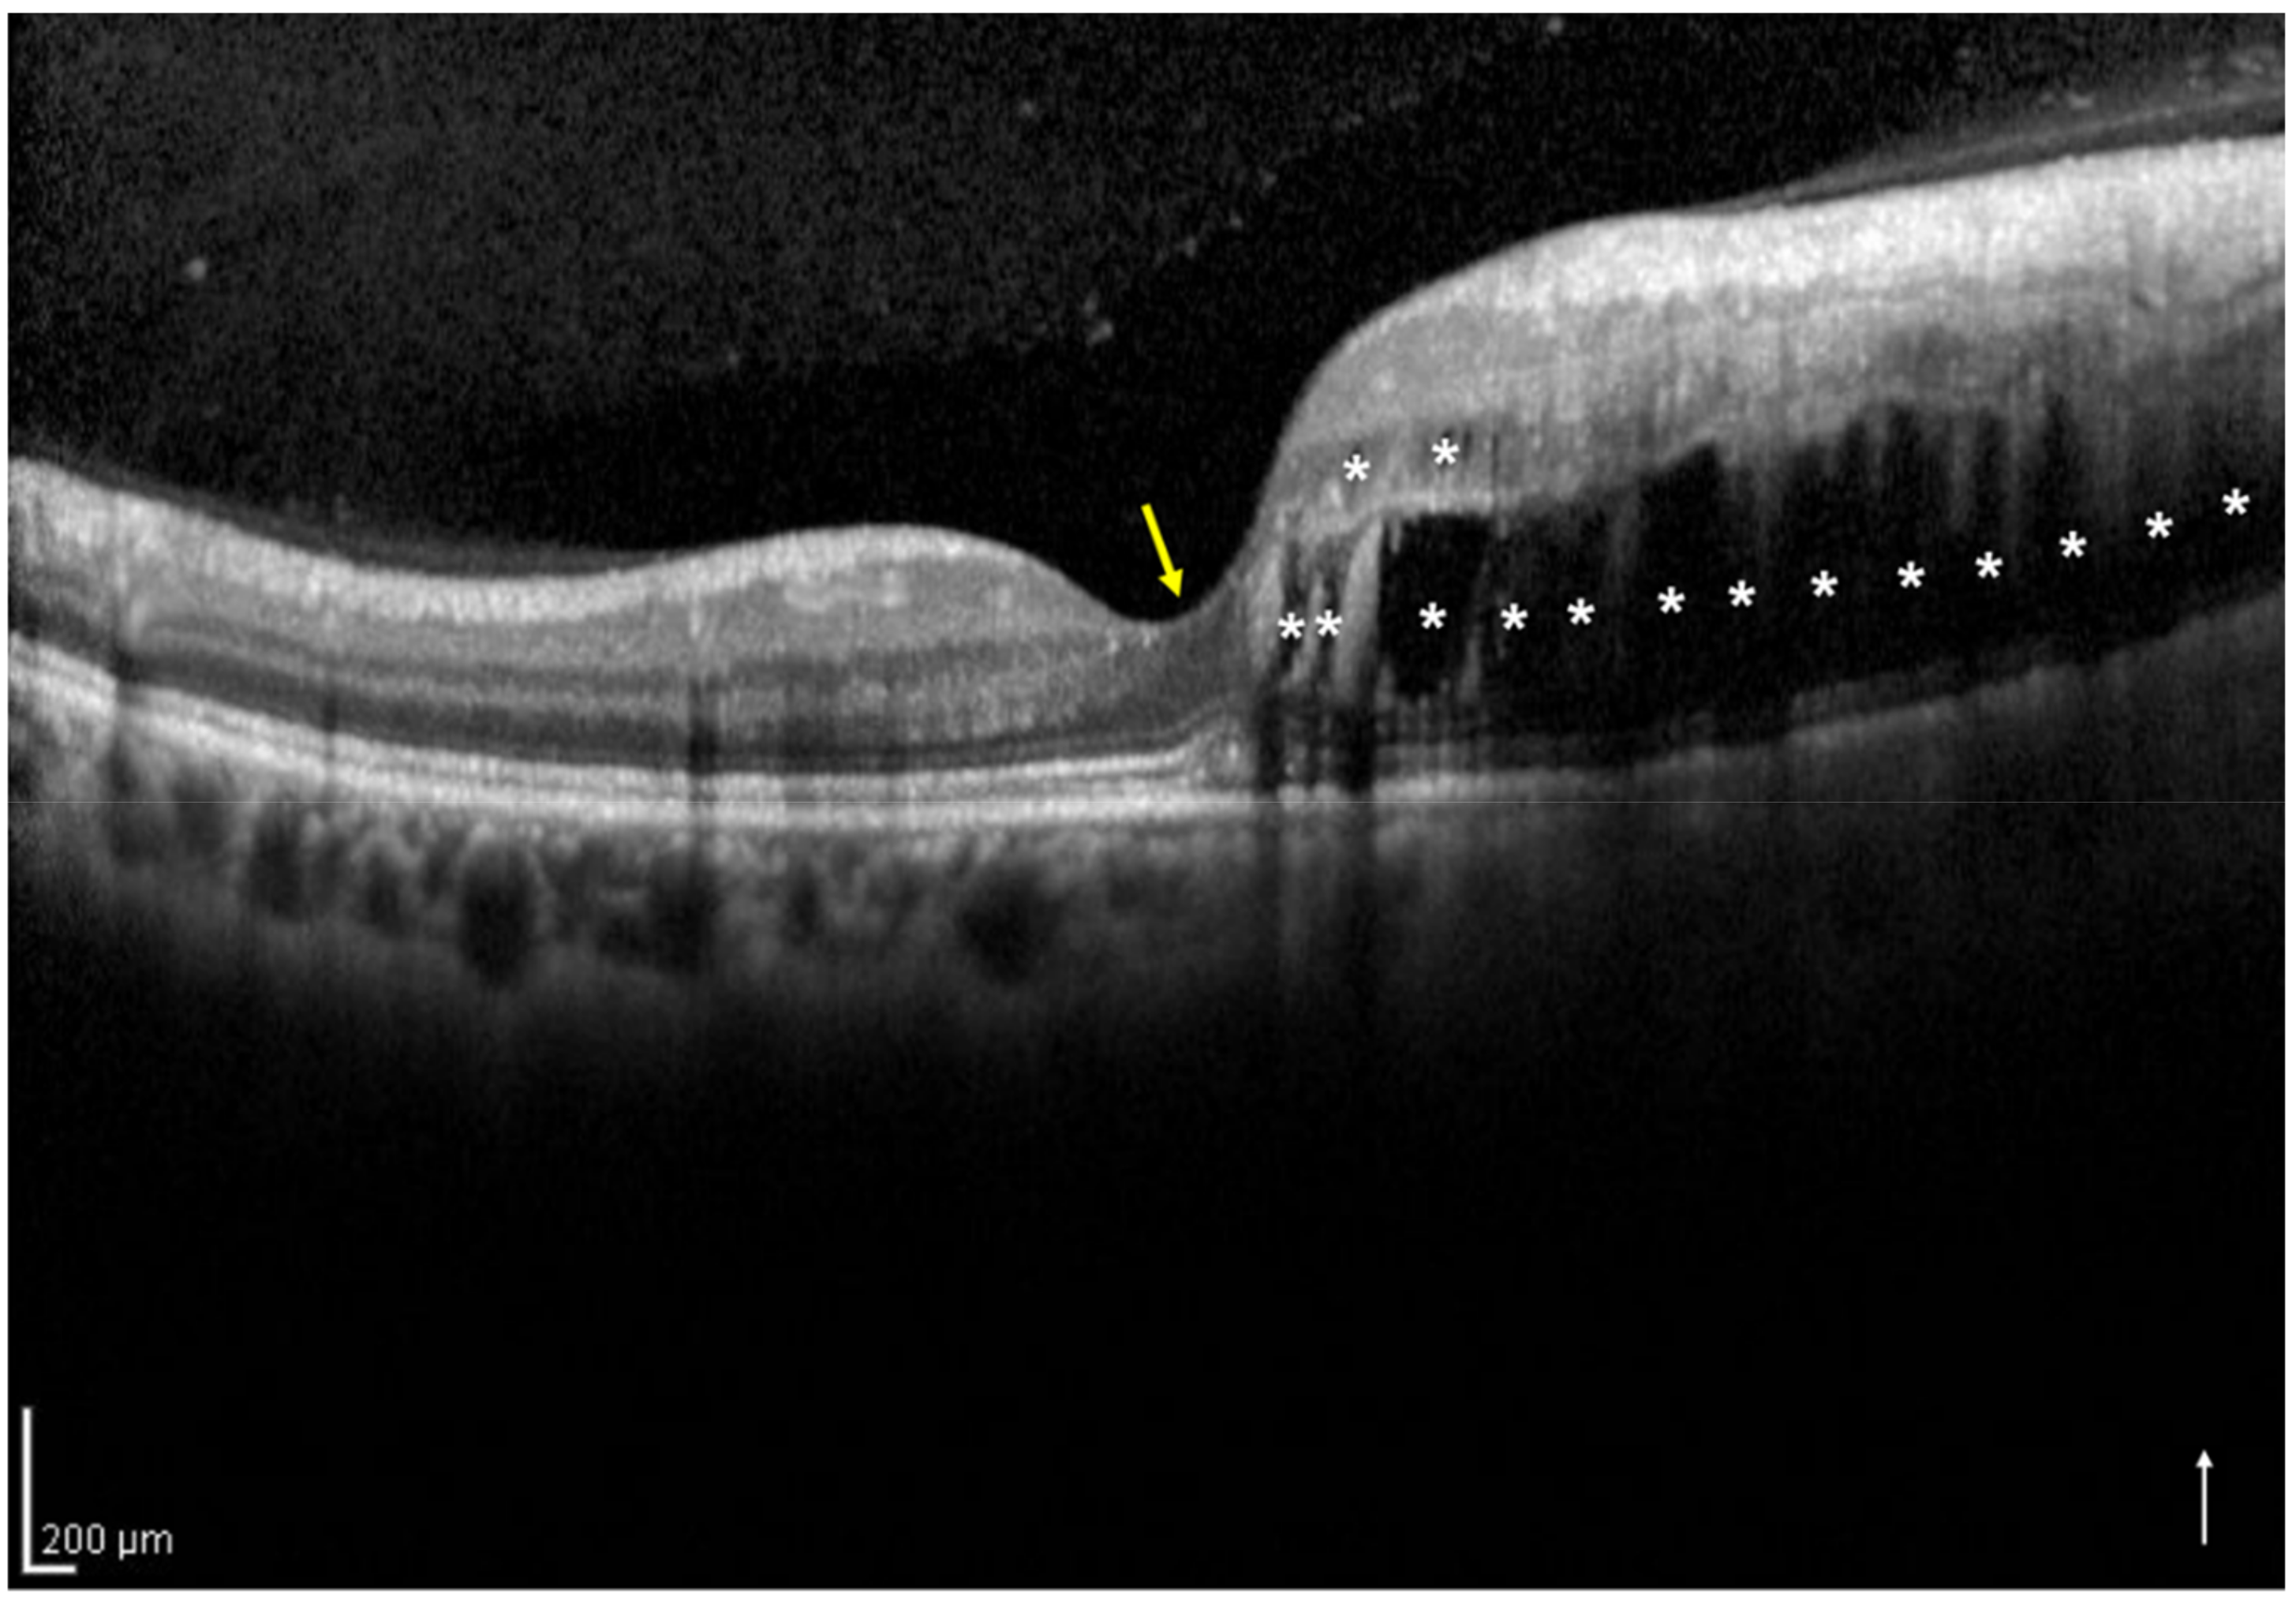
Jcm 11 03540 g001
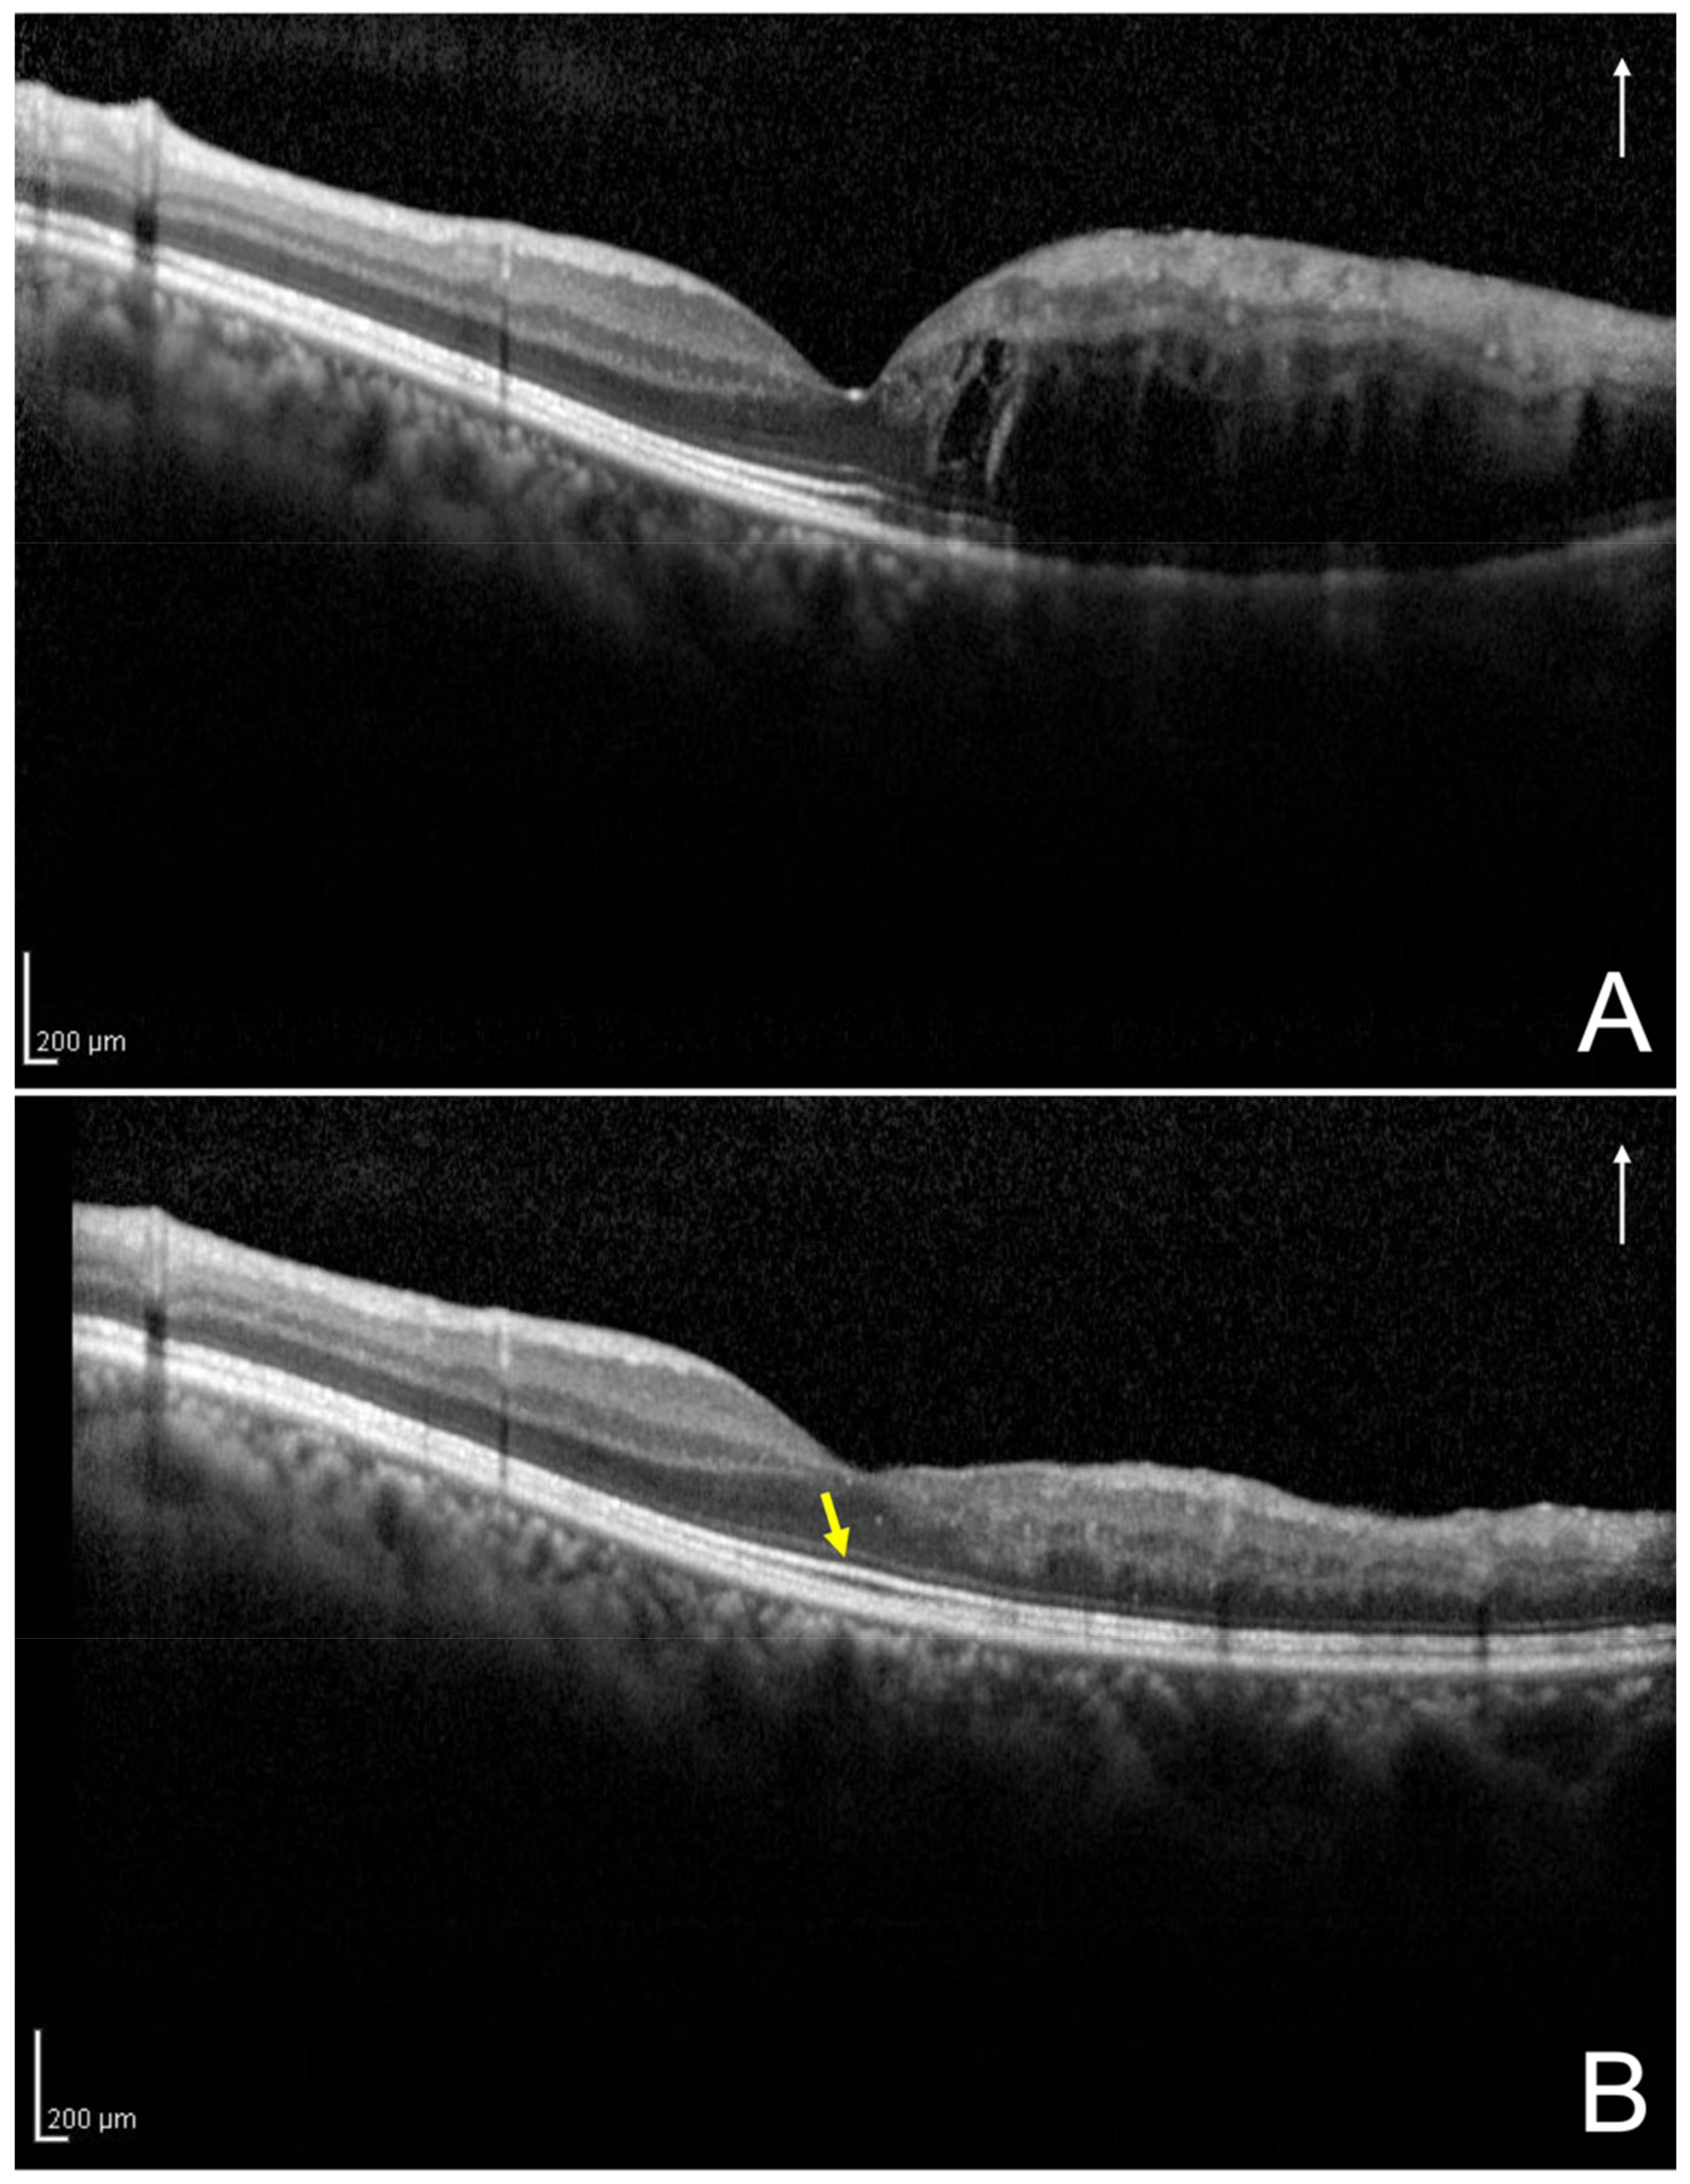
Jcm 11 03540 g003

Foveal Intraretinal Fluid Localization Affects the Visual Prognosis of Branch Retinal Vein Occlusion
Abstract
:1. Introduction
2. Materials and Methods
2.1. Patients
2.2. Examinations
2.3. Definition and Classification of the Two Groups Using Optical Coherence Tomography
2.4. Assessment of the Foveal Ellipsoid Zone Band at 12 Months after the Initial Treatment
2.5. Statistical Analysis
3. Results
3.1. Patient Characteristics
3.2. Comparison of the two Groups According to Foveal Intraretinal Fluid Localization
3.3. Baseline Visual Prognostic Factors Associated with the Visual Acuity at 12 Months
4. Discussion
5. Conclusions
Author Contributions
Funding
Institutional Review Board Statement
Informed Consent Statement
Data Availability Statement
Conflicts of Interest
References
- Kondo, M.; Kondo, N.; Ito, Y.; Kachi, S.; Kikuchi, M.; Yasuma, T.R.; Ota, I.; Kensaku, M.; Terasaki, H. Intravitreal injection of bevacizumab for macular edema secondary to branch retinal vein occlusion: Results after 12 months and multiple regression analysis. Retina 2009, 29, 1242–1248. [Google Scholar] [CrossRef] [PubMed]
- Jaissle, G.B.; Szurman, P.; Feltgen, N.; Spitzer, B.; Pielen, A.; Rehak, M.; Spital, G.; Heimann, H.; Meyer, C.H.; Retinal Vein Occlusion Study Group. Predictive factors for functional improvement after intravitreal bevacizumab therapy for macular edema due to branch retinal vein occlusion. Graefe’s Arch. Clin. Exp. Ophthalmol. 2011, 249, 183–192. [Google Scholar] [CrossRef] [PubMed] [Green Version]
- Iida-Miwa, Y.; Muraoka, Y.; Iida, Y.; Ooto, S.; Murakami, T.; Suzuma, K.; Tsujikawa, A. Branch retinal vein occlusion: Treatment outcomes according to the retinal nonperfusion area, clinical subtype, and crossing pattern. Sci. Rep. 2019, 25, 6569. [Google Scholar] [CrossRef] [PubMed]
- Scott, I.U.; Van Veldhuisen, P.C.; Oden, N.L.; Ip, M.S.; Blodi, B.A.; Hartnett, M.E.; Cohen, G. Standard Care versus Corticosteroid for Retinal Vein Occlusion Study Investigator Group. Baseline predictors of visual acuity and retinal thickness outcomes in patients with retinal vein occlusion: Standard Care Versus Corticosteroid for Retinal Vein Occlusion Study report 10. Ophthalmology 2011, 118, 345–352. [Google Scholar]
- Ota, M.; Tsujikawa, A.; Murakami, T.; Yamaike, N.; Sakamoto, A.; Kotera, Y.; Miyamoto, K.; Kita, M.; Yoshimura, N. Foveal photoreceptor layer in eyes with persistent cystoid macular edema associated with branch retinal vein occlusion. Am. J. Ophthalmol. 2008, 145, 273–280. [Google Scholar] [CrossRef] [Green Version]
- Kriechbaum, K.; Michels, M.; Prager, F.; Georgopoulos, M.; Funk, M.; Geitzenauer, W.; Schmidt-Erfurth, U. Intravitreal avastin for macular oedema secondary to retinal vein occlusion: A prospective study. Br. J. Ophthalmol. 2008, 92, 518–522. [Google Scholar] [CrossRef] [Green Version]
- Hoeh, A.E.; Ruppenstein, M.; Ach, T.; Dithmar, S. OCT patterns of macular edema and response to bevacizumab therapy in retinal vein occlusion. Graefe’s Arch. Clin. Exp. Ophthalmol. 2010, 248, 1567–1572. [Google Scholar] [CrossRef]
- Kang, H.M.; Chung, E.J.; Kim, Y.M.; Koh, H.J. Spectral-domain optical coherence tomography (SD-OCT) patterns and response to intravitreal bevacizumab therapy in macular edema associated with branch retinal vein occlusion. Graefe’s Arch. Clin. Exp. Ophthalmol. 2013, 251, 501–508. [Google Scholar] [CrossRef]
- Shiono, A.; Kogo, J.; Sasaki, H.; Yomoda, R.; Jujo, T.; Tokuda, N.; Kitaoka, Y.; Takagi, H. Optical coherence tomography findings as a predictor of clinical course in patients with branch retinal vein occlusion treated with ranibizumab. PLoS ONE 2018, 13, e0199552. [Google Scholar] [CrossRef] [Green Version]
- Mimouni, M.; Segev, O.; Dori, D.; Geffen, N.; Flores, V.; Segal, O. Disorganization of the retinal inner layers as a predictor of visual acuity in eyes with macular edema secondary to vein occlusion. Am. J. Ophthalmol. 2017, 182, 160–167. [Google Scholar] [CrossRef]
- The Branch Vein Occlusion Study Group. Argon laser photocoagulation for macular edema in branch vein occlusion. Am. J. Ophthalmol. 1984, 98, 271–282. [Google Scholar] [CrossRef]
- Heyreh, S.S.; Zimmerman, M.B. Fundus changes in branch retinal vein occlusion. Retina 2015, 35, 1016–1027. [Google Scholar] [CrossRef] [PubMed] [Green Version]
- Miwa, Y.; Muraoka, Y.; Osaka, R.; Ooto, S.; Murakami, T.; Suzuma, K.; Takahashi, A.; Iida, Y.; Yoshimura, N.; Tsujikawa, A. Ranibizumab for macular edema after branch retinal vein occlusion: One initial injection versus three monthly injections. Retina 2017, 37, 702–709. [Google Scholar] [CrossRef]
- Murata, T.; Kondo, M.; Inoue, M.; Nakao, S.; Osaka, R.; Shiragami, C.; Sogawa, K.; Mochizuki, A.; Shiraga, R.; Ohashi, Y.; et al. The randomized ZIPANGU trial of ranibizumab and adjunct laser for macular edema following branch retinal vein occlusion in treatment-naïve patients. Sci. Rep. 2021, 11, 551. [Google Scholar] [CrossRef] [PubMed]
- Murakami, T.; Tsujikawa, A.; Ohta, M.; Miyamoto, K.; Kita, M.; Watanabe, D.; Takagi, H.; Yoshimura, N. Photoreceptor status after resolved macular edema in branch retinal vein occlusion treated with tissue plasminogen activator. Am. J. Ophthalmol. 2007, 143, 171–173. [Google Scholar] [CrossRef] [PubMed]
- Ota, M.; Tsujikawa, A.; Murakami, T.; Kita, M.; Miyamoto, K.; Sakamoto, A.; Yamaike, N.; Yoshimura, N. Association between integrity of foveal photoreceptor layer and visual acuity in branch retinal vein occlusion. Br. J. Ophthalmol. 2007, 91, 1644–1649. [Google Scholar] [CrossRef] [PubMed]
- Tso, M.O. Pathology of cystoid macular edema. Ophthalmology 1982, 89, 902–915. [Google Scholar] [CrossRef]
- Wallow, I.H.; Danis, R.P.; Bindley, C.; Neider, M. Cystoid macular degeneration in experimental branch retinal vein occlusion. Ophthalmology 1988, 95, 1371–1379. [Google Scholar] [CrossRef]
- Ohashi, H.; Oh, H.; Nishiwaki, H.; Nonaka, A.; Takagi, H. Delayed absorption of macular edema accompanying serous retinal detachment after grid laser treatment in patients with branch retinal vein occlusion. Ophthalmology 2004, 111, 2050–2056. [Google Scholar] [CrossRef]
- Shroff, D.; Mehta, D.K.; Arora, R.; Narula, R.; Chauhan, D. Natural history of macular status in recent-onset branch retinal vein occlusion: An optical coherence tomography study. Int. Ophthalmol. 2008, 28, 261–268. [Google Scholar] [CrossRef]
- Tsujikawa, A.; Sakamoto, A.; Ota, M.; Kotera, Y.; Oh, H.; Miyamoto, K.; Kita, M.; Yoshimura, N. Serous retinal detachment associated with retinal vein occlusion. Am. J. Ophthalmol. 2010, 149, 291–301.e5. [Google Scholar] [CrossRef] [PubMed]
- Iijima, H. Mechanisms of vision loss in eyes with macular edema associated with retinal vein occlusion. Jpn. J. Ophthalmol. 2018, 62, 265–273. [Google Scholar] [CrossRef] [PubMed]

| Parameters | Value | p-Value |
|---|---|---|
| No. of eyes | 50 | |
| Baseline | ||
| Age (years) | 67.2 ± 12 | |
| Sex (male/female) | 16/34 | |
| Eye (right/left) | 22/28 | |
| No. of cases of hypertension (%) | 24 (48) | |
| No. of cases of diabetes mellitus (%) | 9 (18) | |
| No. of cases of dyslipidemia (%) | 10 (20) | |
| BRVO subtype (major/macular) | 42/8 | |
| Perfusion status (ischemic/non-ischemic) | 32/18 | |
| Hemorrhage area (mm2) 1 | 155.3 ± 92.7 | |
| No. of cases of scatter laser photocoagulations (%) | 22 (44) | |
| Duration before initial treatment (weeks) | 5.4 ± 5.1 | |
| Total no. of injections | 3.9 ± 1.6 | |
| No. of eyes with one-side IRF/both-sides IRF | 33/17 | |
| LogMAR BCVA | 0.29 ± 0.27 | |
| Central subfield thickness (μm) | 512.2 ± 137 | |
| Presence of subretinal fluid (%) | 21 (42) | |
| 12 months following the initial treatment | ||
| LogMAR BCVA | 0.061 ± 0.2 | <0.001 * |
| Central subfield thickness (μm) | 336.5 ± 112.2 | <0.001 * |
| Presence of subretinal fluid (%) | 1 (2) | |
| No. of eyes with foveal EZ band disruption (%) | 9 (18) |
| Parameters | One-Side IRF | Both-Sides IRF | p-Value |
|---|---|---|---|
| No. of eyes | 33 | 17 | |
| Baseline | |||
| Age (years) | 66.7 ± 11.3 | 68.1 ± 13.5 | 0.71 |
| BRVO subtype (major/macular) | 26/7 | 16/1 | 0.24 |
| Perfusion status (ischemic/non-ischemic) | 21/12 | 11/6 | 1 |
| Hemorrhage area (mm2) 1 | 145.4 ± 94.0 | 159.4 ± 95.8 | 0.52 |
| Duration before initial treatment (weeks) | 5.1 ± 5.7 | 6.1 ± 3.7 | 0.15 |
| Total no. of injections | 3.8 ± 1.6 | 4.1 ± 1.5 | 0.4 |
| LogMAR BCVA | 0.21 ± 0.2 | 0.43 ± 0.4 | 0.028 |
| Central subfield thickness (μm) | 464.5 ± 125.9 | 604.7 ± 109.6 | <0.001 |
| Presence of subretinal fluid (%) | 9 (27.3) | 12 (70.6) | 0.006 |
| 12 months following the initial treatment | |||
| LogMAR BCVA | −0.023 ± 0.1 | 0.22 ± 0.2 | <0.001 |
| Central subfield thickness (μm) | 321.5 ± 95.8 | 365.5 ± 137.4 | 0.26 |
| Presence of subretinal fluid (%) | 0 (0) | 1 (5.9) | 0.34 |
| No. of eyes with foveal EZ band disruption (%) | 1 (3.0) | 8 (47.1) | <0.001 |
| No. of eyes with decimal BCVA of ≧0.5 (%) | 33 (100) | 12 (70.6) | 0.003 |
| Explanatory Variables | Coefficient (95% CI) | p-Value | Standardized Coefficient |
|---|---|---|---|
| Both-sides IRF (compared to one-side IRF) | 0.19 (0.078 to 0.29) | 0.001 | 0.455 |
| LogMAR BCVA | 0.2 (0.01 to 0.4) | 0.04 | 0.28 |
| Age (years) | 0.003 (−0.001 to 0.007) | 0.19 | 0.166 |
| Central subfield thickness (μm) | 0.00001 (−0.0004 to 0.0004) | 0.96 | −0.008 |
| Subretinal fluid (presence) | 0.03 (−0.082 to 0.14) | 0.59 | 0.077 |
Publisher’s Note: MDPI stays neutral with regard to jurisdictional claims in published maps and institutional affiliations. |
© 2022 by the authors. Licensee MDPI, Basel, Switzerland. This article is an open access article distributed under the terms and conditions of the Creative Commons Attribution (CC BY) license (https://creativecommons.org/licenses/by/4.0/).
Share and Cite
Sasajima, H.; Zako, M.; Maeda, R.; Murotani, K.; Ishida, H.; Ueta, Y. Foveal Intraretinal Fluid Localization Affects the Visual Prognosis of Branch Retinal Vein Occlusion. J. Clin. Med. 2022, 11, 3540. https://doi.org/10.3390/jcm11123540
Sasajima H, Zako M, Maeda R, Murotani K, Ishida H, Ueta Y. Foveal Intraretinal Fluid Localization Affects the Visual Prognosis of Branch Retinal Vein Occlusion. Journal of Clinical Medicine. 2022; 11(12):3540. https://doi.org/10.3390/jcm11123540
Chicago/Turabian StyleSasajima, Hirofumi, Masahiro Zako, Rio Maeda, Kenta Murotani, Hidetoshi Ishida, and Yoshiki Ueta. 2022. "Foveal Intraretinal Fluid Localization Affects the Visual Prognosis of Branch Retinal Vein Occlusion" Journal of Clinical Medicine 11, no. 12: 3540. https://doi.org/10.3390/jcm11123540
APA StyleSasajima, H., Zako, M., Maeda, R., Murotani, K., Ishida, H., & Ueta, Y. (2022). Foveal Intraretinal Fluid Localization Affects the Visual Prognosis of Branch Retinal Vein Occlusion. Journal of Clinical Medicine, 11(12), 3540. https://doi.org/10.3390/jcm11123540

